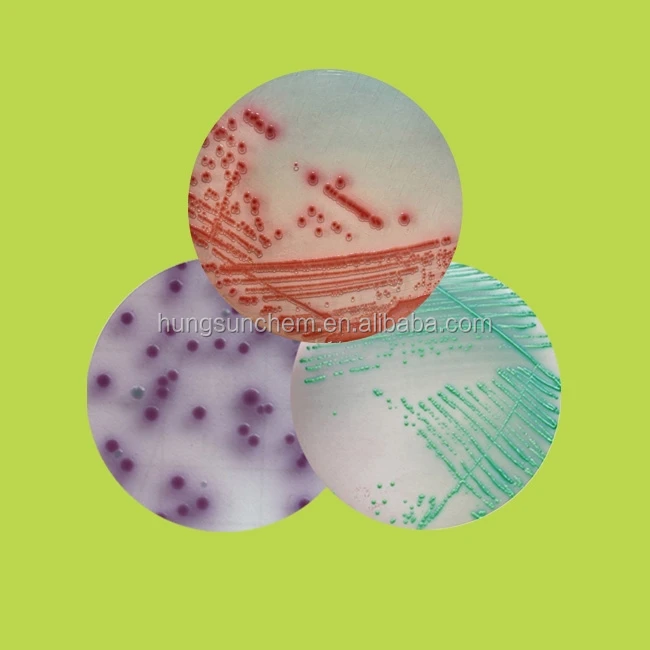

Chromogenic Culture Media, Chromogenic Salmonella Agar for microbiological diagnostic
Quick Details Port: Shanghai Payment Terms: L/C,D/A,D/P,T/T,Western Union Supply Ability: 1000 Kilogram/Kilograms per Week color: light yellow Physical behavior: Powder Classification: Other,Other Reagent grade: Biochemical Reagent type: Chromegenic Salmonella Agar Delivery Detail: Shipped in 0 days after payment Packaging Detail: 500g/bottle Product Description CRM004 Salmonella Chromogenic Medium (Chromogenic Salmonella Agar) Usages: For rapid isolation and identification of Salmonella. (GB4789.40-2010) Principle: Ability antibacterial agents against Gram-positive bacteria, and enhance the medium inhibit bacteria; peptone and yeast extract powder provides carbon and nitrogen sources and trace elements; sodium chloride maintains osmotic equilibrium; agar culture medium coagulant ; mixing pigment with Salmonella and coliforms, respectively corresponding to the occurrence of a specific enzyme reaction, hydrolysis of the substrate, the release of the color groups in the pale yellow tablet Salmonella produce magenta colonies, coliform produce blue-green colonies . Formulation (per liter): Peptone :19.6g Yeast extract powde:r 3g Sodium chloride: 5g Bacteriostatic agent :1.5g Agar :12g Mixed Pigment: 6.4g Final pH 7.0 ± 0.2 How to use: 1. Weigh 47.5g the product, dissolved in 1000ml distilled or purified water, mixed and heated to 100 °C, stirring constantly until the regular press completely dissolved (can not be heated to high […]